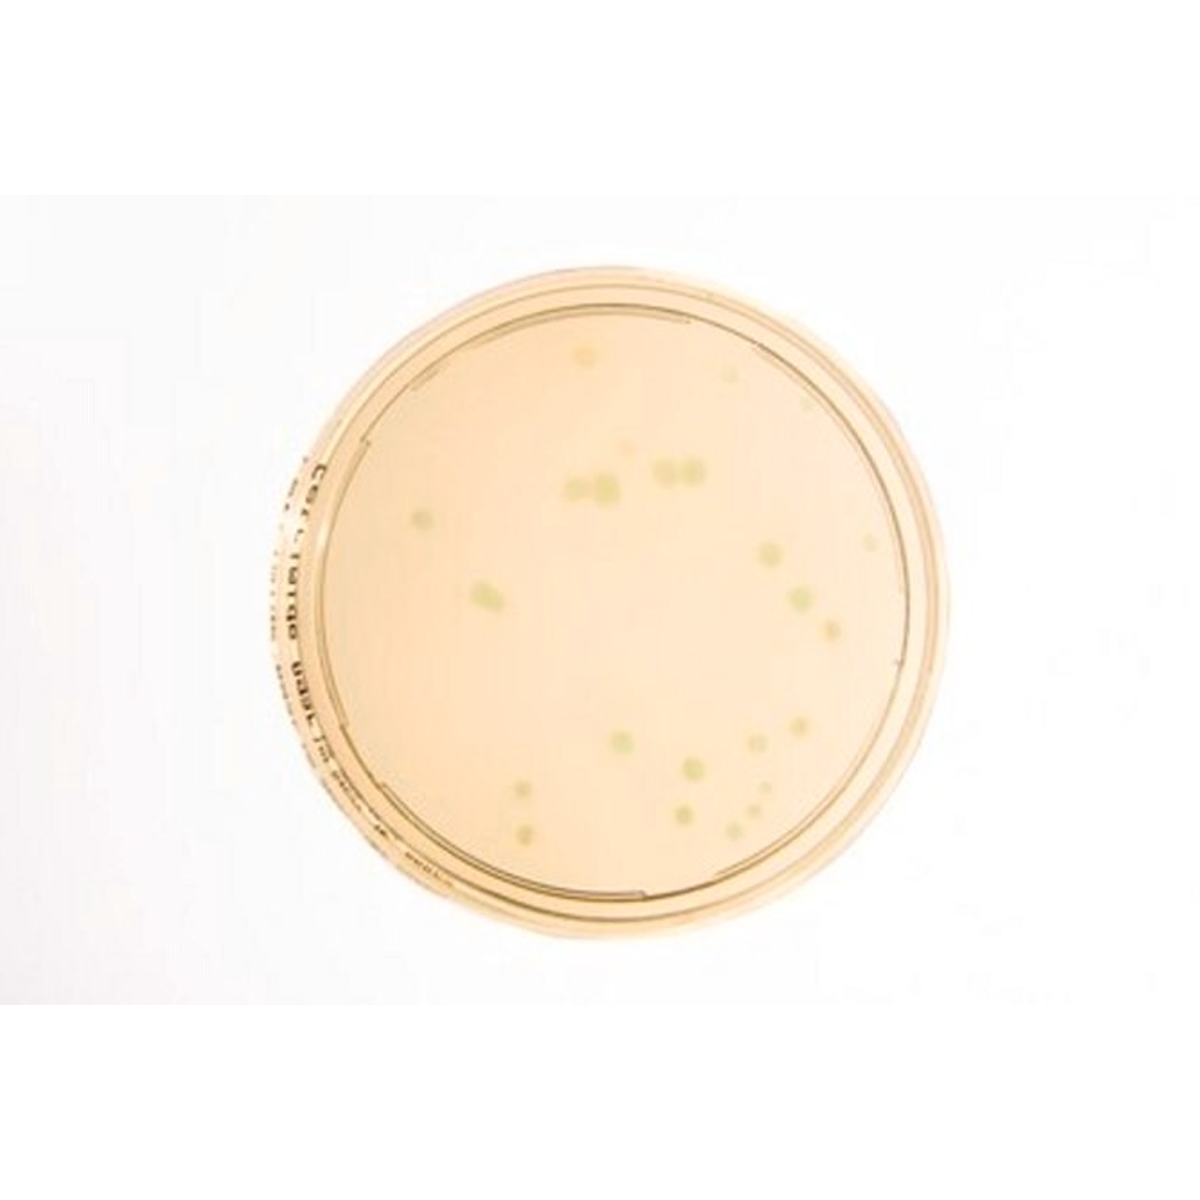

1
/
of
1
SKU:1460480020
Merck
HEIMPLATE Cetrimide agar
HEIMPLATE Cetrimide agar
Out of stock
Product description
Product description
Heimplate, EP, USP, JP, plate diam. 90 mm, ICR Settle Plate for long Incubation, suitable for microbiology
Additional information
Additional information